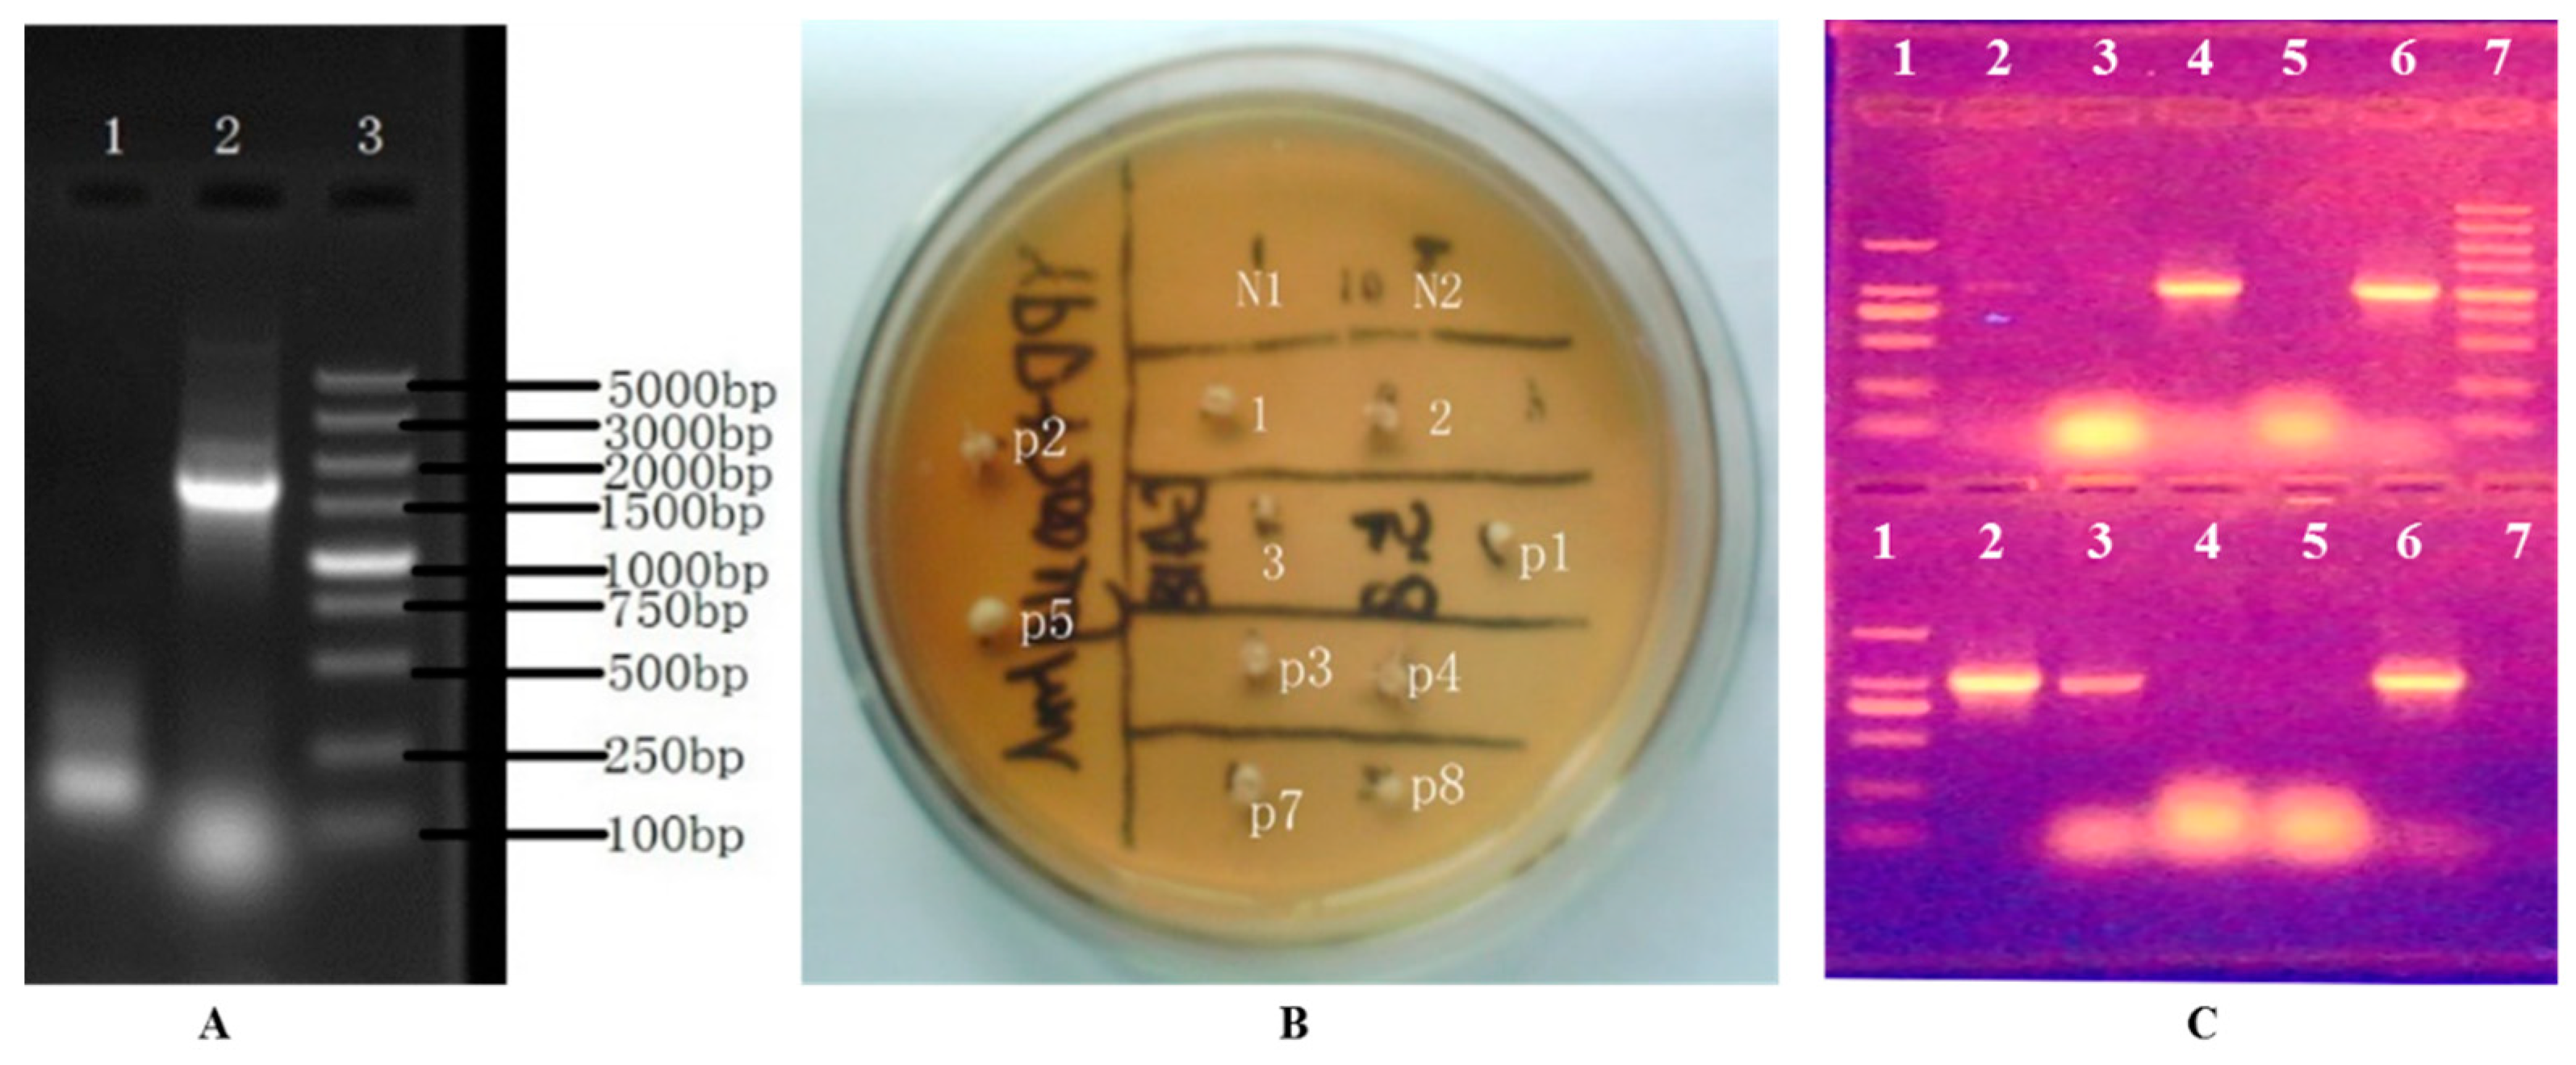

The Effects of Catabolism Relationships of Leucine and Isoleucine with BAT2 Gene of Saccharomyces cerevisiae on High Alcohols and Esters
Abstract
:1. Introduction
2. Materials and Methods
2.1. Materials
2.1.1. Strain and Vector
2.1.2. Enzyme and Reagents
2.2. Cloning and Sequencing of the BAT2 Gene of S. cerevisiae 38
2.3. Construction of the BAT2 Gene-Deletion Cassette through LPSHR
2.4. Deletion of the BAT2 Gene of Parental S. cerevisiae 38
2.4.1. Transformation of the BAT2 Deletion Cassette
2.4.2. Selection and Verification of the Transformants
2.5. Metabolites Analyses of Ile and Leu as Sole Nitrogen Sources
2.5.1. Design of the High-Concentration Gradient Supply of Ile and Leu in Media
2.5.2. Metabolite Analyses
2.5.3. Energy Metabolism Analysis
3. Results
3.1. Sequencing and Deletion of the BAT2 Gene Using the LPSHR Method
3.2. Catabolic Analyses of Ile and Leu
3.2.1. Catabolic Analyses of Ile
3.2.2. Metabolic Regulation of Leu
4. Discussion
4.1. Effects of BAT2 Sequence Difference on Bat2p Activity for Leu and Ile
4.2. Effects of Ile or Leu Addition and BAT2 Gene on High Alcohols and Esters
5. Conclusions
Supplementary Materials
Author Contributions
Funding
Institutional Review Board Statement
Informed Consent Statement
Data Availability Statement
Conflicts of Interest
References
- Wu, S.; Yang, J.; Dong, H.; Liu, Q.; Li, X.; Zeng, X.; Bai, W. Key Aroma Compounds of Chinese Dry-Cured Spanish Mackerel (Scomberomorus niphonius) and Their Potential Metabolic Mechanisms. Food Chem. 2021, 342, 128381. [Google Scholar] [CrossRef] [PubMed]
- Yoshimoto, H.; Fukushige, T.; Yonezawa, T.; Sone, H. Genetic and Physiological Analysis of Branched-Chain Alcohols and Isoamyl Acetate Production in Saccharomyces cerevisiae. Appl. Microbiol. Biotechnol. 2002, 59, 501–508. [Google Scholar] [PubMed]
- Zhang, C.-Y.; Qi, Y.-N.; Ma, H.-X.; Li, W.; Dai, L.-H.; Xiao, D.-G. Decreased production of higher alcohols by Saccharomyces cerevisiae for Chinese rice wine fermentation by deletion of Bat aminotransferases. J. Ind. Microbiol. Biotechnol. 2015, 42, 617–625. [Google Scholar] [CrossRef] [PubMed]
- Hammer, S.K.; Avalos, J.L. Uncovering the role of branched-chain amino acid transaminases in Saccharomyces cerevisiae isobutanol biosynthesis. Metab. Eng. 2017, 44, 302–312. [Google Scholar] [CrossRef] [PubMed]
- Lilly, M.; Bauer, F.F.; Styger, G.; Lambrechts, M.G.; Pretorius, I.S. The effect of increased branched-chain amino acid transaminase activity in yeast on the production of higher alcohols and on the flavour profiles of wine and distillates. FEMS Yeast Res. 2006, 6, 726–743. [Google Scholar] [CrossRef] [Green Version]
- Pires, E.J.; Teixeira, J.A.; Brányik, T.; Vicente, A.A. Yeast: The Soul of Beer’s Aroma—A Review of Flavour-Active Esters and Higher Alcohols Produced by the Brewing Yeast. Appl. Microbiol. Biotechnol. 2014, 98, 1937–1949. [Google Scholar] [CrossRef] [Green Version]
- Kispal, G.; Steiner, H.; Rolinski, B.; Lill, R. Mitochondrial and cytosolic branched-chain amino acid transaminases from yeast, homologs of the myc oncogene-regulated Eca39 protein. J. Biol. Chem. 1996, 271, 24458–24464. [Google Scholar] [CrossRef] [Green Version]
- Liu, P.-T.; Yu, K.-J.; Li, Y.-T.; Duan, C.-Q.; Yan, G.-L. The content of linoleic acid in grape must influences the aromatic effect of branched-chain amino acids addition on red wine. Food Res. Int. 2018, 114, 214–222. [Google Scholar] [CrossRef]
- Ma, L.; Huang, S.; Du, L.; Tang, P.; Xiao, D. Reduced production of higher alcohols by Saccharomyces cerevisiae in red wine fermentation by simultaneously overexpressing BAT1 and deleting BAT2. J. Agric. Food Chem. 2017, 65, 6936–6942. [Google Scholar] [CrossRef]
- Hu, Z.; Li, X.; Wang, H.; Niu, C.; Yuan, Y.; Yue, T. A novel method to quantify the activity of alcohol acetyltransferase Using a SnO2-based sensor of electronic nose. Food Chem. 2016, 203, 498–504. [Google Scholar] [CrossRef]
- Gueldener, U.; Heinisch, J.; Koehler, G.J.; Voss, D.; Hegemann, J.H. A second set of loxP marker cassettes for Cre-mediated multiple gene knockouts in budding yeast. Nucleic Acids Res. 2002, 30, e23. [Google Scholar] [CrossRef] [PubMed] [Green Version]
- Duina, A.A.; Miller, M.E.; Keeney, J.B. Budding Yeast for Budding Geneticists: A Primer on the Saccharomyces cerevisiae Model System. Genetics 2014, 197, 33–48. [Google Scholar] [CrossRef] [PubMed] [Green Version]
- Gietz, R.D.; Schiestl, R.H. Frozen competent yeast cells that can be transformed with high efficiency using the LiAc/SS carrier DNA/PEG method. Nat. Protoc. 2007, 2, 1–4. [Google Scholar] [CrossRef] [PubMed]
- Gietz, R.D.; Woods, R.A. Transformation of yeast by lithium acetate/single-stranded carrier DNA/polyethylene glycol method. Methods Enzymol. 2002, 350, 87–96. [Google Scholar]
- Dong, C.; Wang, W. Headspace solid-phase microextraction applied to the simultaneous determination of sorbic and benzoic acids in beverages. Anal. Chim. Acta 2006, 562, 23–29. [Google Scholar] [CrossRef]
- Guan, F.; Watanabe, K.; Ishii, A.; Seno, H.; Kumazawa, T.; Hattori, H.; Suzuki, O. Headspace solid-phase microextraction and gas chromatographic determination of dinitroaniline herbicides in human blood, urine and environmental water. J. Chromatogr. B Biomed. Sci. Appl. 1998, 714, 205–213. [Google Scholar] [CrossRef]
- Comuzzo, P.; Tat, L.; Tonizzo, A.; Battistutta, F. Yeast derivatives (extracts and autolysates) in winemaking: Release of volatile compounds and effects on wine aroma volatility. Food Chem. 2006, 99, 217–230. [Google Scholar] [CrossRef]
- Jaffrès, E.; Lalanne, V.; Macé, S.; Cornet, J.; Cardinal, M.; Sérot, T.; Dousset, X.; Joffraud, J.-J. Sensory characteristics of spoilage and volatile compounds associated with bacteria isolated from cooked and peeled tropical shrimps using SPME–GC–MS analysis. Int. J. Food Microbiol. 2011, 147, 195–202. [Google Scholar] [CrossRef] [Green Version]
- Malherbe, S.; Watts, V.; Nieuwoudt, H.H.; Bauer, F.F.; du Toit, M. Analysis of Volatile Profiles of Fermenting Grape Must by Headspace Solid-Phase Dynamic Extraction Coupled with Gas Chromatography−Mass Spectrometry (HS-SPDE GC-MS): Novel Application To Investigate Problem Fermentations. J. Agric. Food Chem. 2009, 57, 5161–5166. [Google Scholar] [CrossRef]
- Zhu, J.C.; Wang, L.Y.; Xiao, Z.B.; Niu, Y.W. Characterization of the key aroma compounds in mulberry fruits by application of gas chromatography-olfactometry (GC-O), odor activity value (OAV), gas chromatography-mass spectrometry (GC-MS) and flame photometric detection (FPD). Food Chem. 2017, 245, 775–785. [Google Scholar] [CrossRef]
- Dong, L.; Piao, Y.; Zhang, X.; Zhao, C.; Hou, Y.; Shi, Z. Analysis of volatile compounds from a malting process using headspace solid-phase micro-extraction and GC–MS. Food Res. Int. 2013, 51, 783–789. [Google Scholar] [CrossRef]
- Hu, Z.; Li, L.; Yuan, Y.; Yue, T. Ultrasensitive and simultaneous determination of twenty-one amino acids and amines in culture media, red wine and beer. Food Chem. 2014, 158, 56–65. [Google Scholar] [CrossRef] [PubMed]
- Kuttel, M.; Gordon, M.; Ravenscroft, N. Comparative simulation of pneumococcal serogroup 19 polysaccharide repeating units with two carbohydrate force fields. Carbohydr. Res. 2014, 390, 20–27. [Google Scholar] [CrossRef] [PubMed]
- Xiong, X.; Chen, Z.; Cossins, B.P.; Xu, Z.; Shao, Q.; Ding, K.; Zhu, W.; Shi, J. Force fields and scoring functions for carbohydrate simulation. Carbohydr. Res. 2015, 401, 73–81. [Google Scholar] [CrossRef] [PubMed]
- Etschmann, M.M.W.; Kötter, P.; Hauf, J.; Bluemke, W.; Entian, K.D.; Schrader, J. Production of the Aroma Chemicals 3-(Methylthio)-1-Propanol and 3-(Methylthio)-Propylacetate with Yeasts. Appl. Microbiol. Biotechnol. 2008, 80, 579–587. [Google Scholar] [CrossRef]
- Styger, G.; Jacobson, D.; Bauer, F. Identifying Genes That Impact on Aroma Profiles Produced by Saccharomyces cerevisiae and the Production of Higher Alcohols. Appl. Microbiol. Biotechnol. 2011, 91, 713–730. [Google Scholar] [CrossRef] [Green Version]
- Karabín, M.; Jelínek, L.; Kotrba, P.; Cejnar, R.; Dostálek, P. Enhancing the performance of brewing yeasts. Biotechnol. Adv. 2018, 36, 691–706. [Google Scholar] [CrossRef]
- Tapiero, H.; Mathé, G.; Couvreur, P.; Tew, K.D. II Glutamine and glutamate. Biomed. Pharmacother. 2002, 56, 446–457. [Google Scholar] [CrossRef]
- Avalos, J.L.; Fink, G.R.; Stephanopoulos, G. Compartmentalization of metabolic pathways in yeast mitochondria improves the production of branched-chain alcohols. Nat. Biotech. 2013, 31, 335–341. [Google Scholar] [CrossRef] [Green Version]
- Gregoret, L.M.; Sauer, R.T. Tolerance of a protein helix to multiple alanine and valine substitutions. Fold Des. 1998, 3, 119–126. [Google Scholar] [CrossRef] [Green Version]
- Fitts, R.; Reuveny, Z.; van Amsterdam, J.; Mulholland, J.; Botstein, D. Substitution of tyrosine for either cysteine in beta-lactamase prevents release from the membrane during secretion. Proc. Natl. Acad. Sci. USA 1987, 84, 8540. [Google Scholar] [CrossRef] [Green Version]
- Kyte, J.; Doolittle, R.F. A simple method for displaying the hydropathic character of a protein. J. Mol. Biol. 1982, 157, 105–132. [Google Scholar] [CrossRef] [Green Version]
- Kastritis, P.L.; Visscher, K.M.; van Dijk, A.D.; Bonvin, A.M. Solvated protein-protein docking using Kyte-Doolittle-based water preferences. Proteins Struct. Funct. Bioinform. 2013, 81, 510. [Google Scholar] [CrossRef] [Green Version]
- Hopp, T.P.; Woods, K.R. A computer program for predicting protein antigenic determinants. Mol. Immunol. 1983, 20, 483–489. [Google Scholar] [CrossRef]
- Wan, C.-S.; Zhou, Y.; Yu, Y.; Peng, L.J.; Zhao, W.; Zheng, X.-l. B-cell epitope KT-12 of enterohemorrhagic Escherichia coli O157:H7: A novel peptide vaccine candidate. Microbiol. Immunol. 2011, 55, 247–253. [Google Scholar] [CrossRef]
- Lin, Y.; Long, H.; Wang, J.; Shu, M.; Wang, Y.; Wang, L.; Lin, Z. QSAR Study on Insect Neuropeptide Potencies Based on a Novel Set of Parameters of Amino Acids by Using OSC-PLS Method. Int. J. Pept. Res. Ther. 2011, 17, 201–208. [Google Scholar] [CrossRef]
- Brem, R.B.; Yvert, G.; Clinton, R.; Kruglyak, L. Genetic Dissection of Transcriptional Regulation in Budding Yeast. Science 2002, 296, 752–755. [Google Scholar] [CrossRef] [Green Version]
- Zheng, D.-Q.; Chen, J.; Zhang, K.; Gao, K.-H.; Li, O.; Wang, P.-M.; Zhang, X.-Y.; Du, F.-G.; Sun, P.-Y.; Qu, A.-M.; et al. Genomic structural variations contribute to trait improvement during whole-genome shuffling of yeast. Appl. Microbiol. Biotechnol. 2014, 98, 3059–3070. [Google Scholar] [CrossRef]
- Sattelle, B.M.; Almond, A. Less is more when simulating unsulfated glycosaminoglycan 3D-structure: Comparison of GLYCAM06/TIP3P, PM3-CARB1/TIP3P, and SCC-DFTB-D/TIP3P predictions with experiment. J. Comput. Chem. 2010, 31, 2932–2947. [Google Scholar] [CrossRef]
- Dayma, G.; Togbé, C.; Dagaut, P. Experimental and Detailed Kinetic Modeling Study of Isoamyl Alcohol (Isopentanol) Oxidation in a Jet-Stirred Reactor at Elevated Pressure. Energy Fuels 2011, 25, 4986–4998. [Google Scholar] [CrossRef]
- Chen, Y.; Tan, T. Enhanced S-Adenosylmethionine Production by Increasing ATP Levels in Baker’s Yeast (Saccharomyces cerevisiae). J. Agric. Food. Chem. 2018, 66, 5200–5209. [Google Scholar] [CrossRef]
- Osorio-Viana, W.; Ibarra-Taquez, H.N.; Dobrosz-Gómez, I.; Gómez-García, M.Á. Hybrid membrane and conventional processes comparison for isoamyl acetate production. Chem. Eng. Processing Process Intensif. 2014, 76, 70–82. [Google Scholar] [CrossRef]
- Gamero, A.; Ferreira, V.; Pretorius, I.; Querol, A. Wine, Beer and Cider: Unravelling the Aroma Profile. In Molecular Mechanisms in Yeast Carbon Metabolism; Piškur, J., Compagno, C., Eds.; Springer: Berlin/Heidelberg, Germany, 2014; pp. 261–297. [Google Scholar] [CrossRef]
- Nikonorova, I.A.; Mirek, E.T.; Signore, C.C.; Goudie, M.P.; Wek, R.C.; Anthony, T.G. Time-resolved analysis of amino acid stress identifies eIF2 phosphorylation as necessary to inhibit mTORC1 activity in liver. J. Biol. Chem. 2018, 293, 5005–5015. [Google Scholar] [CrossRef] [Green Version]
- Meng, J.; Ferguson, S.M. GATOR1-dependent recruitment of FLCN–FNIP to lysosomes coordinates Rag GTPase heterodimer nucleotide status in response to amino acids. J. Cell Biol. 2018, 217, 2765–2776. [Google Scholar] [CrossRef]
- Zhang, A.; Li, Y.; Gao, Y.; Jin, H. Increasing isobutanol yield by double-gene deletion of PDC6 and LPD1 in Saccharomyces cerevisiae. Chin. J. Chem. Eng. 2016, 24, 1074–1079. [Google Scholar] [CrossRef]
- Nicastro, R.; Tripodi, F.; Guzzi, C.; Reghellin, V.; Khoomrung, S.; Capusoni, C.; Compagno, C.; Airoldi, C.; Nielsen, J.; Alberghina, L.; et al. Enhanced amino acid utilization sustains growth of cells lacking Snf1/AMPK. Biochim. Biophys. Acta (BBA) Mol. Cell Res. 2015, 1853, 1615–1625. [Google Scholar] [CrossRef] [Green Version]
- Yu, A.-Q.; Pratomo Juwono, N.K.; Foo, J.L.; Leong, S.S.J.; Chang, M.W. Metabolic engineering of Saccharomyces cerevisiae for the overproduction of short branched-chain fatty acids. Metab. Eng. 2016, 34, 36–43. [Google Scholar] [CrossRef]
- Zhang, C.-Y.; Liu, Y.-L.; Qi, Y.-N.; Zhang, J.-W.; Dai, L.-H.; Lin, X.; Xiao, D.-G. Increased esters and decreased higher alcohols production by engineered brewer’s yeast strains. Eur. Food Res. Technol. 2013, 236, 1009–1014. [Google Scholar] [CrossRef]
- Sumby, K.M.; Grbin, P.R.; Jiranek, V. Microbial modulation of aromatic esters in wine: Current knowledge and future prospects. Food Chem. 2010, 121, 1–16. [Google Scholar] [CrossRef]

| No. | Primers | Sequence (5′→3′) |
|---|---|---|
| 1 | Fw-1 | ATTTGCGGCCGCTATCTAATCTGTAGATCCGACT |
| 2 | Rv-2 | ATTTGCGGCCGCCTTCTAAGGTATGTATGGGC |
| 3 | Bat2-deletion-FW | ACCCGTCTCCCCTCAAGATACCAGCATTGCTCCCTCCAACTACTCCAGCTGAAGCTTCGTACGC |
| 4 | Bat2-deletion-RV | CTGATAGGCCAGCACTAGATGACAAGAAAAAAAACGAAAGGATAAGCATAGGCCACTAGTGGATCTG |
| 5 | fw-bat2-2 | TCTAAGCCAAAACCGAAC |
| 6 | rv-bat2-2 | CTTGACCAATTGCCATGC |
Publisher’s Note: MDPI stays neutral with regard to jurisdictional claims in published maps and institutional affiliations. |
© 2022 by the authors. Licensee MDPI, Basel, Switzerland. This article is an open access article distributed under the terms and conditions of the Creative Commons Attribution (CC BY) license (https://creativecommons.org/licenses/by/4.0/).
Share and Cite
Zhang, L.; Zhang, Y.; Hu, Z. The Effects of Catabolism Relationships of Leucine and Isoleucine with BAT2 Gene of Saccharomyces cerevisiae on High Alcohols and Esters. Genes 2022, 13, 1178. https://doi.org/10.3390/genes13071178
Zhang L, Zhang Y, Hu Z. The Effects of Catabolism Relationships of Leucine and Isoleucine with BAT2 Gene of Saccharomyces cerevisiae on High Alcohols and Esters. Genes. 2022; 13(7):1178. https://doi.org/10.3390/genes13071178
Chicago/Turabian StyleZhang, Lin, Yiqian Zhang, and Zhongqiu Hu. 2022. "The Effects of Catabolism Relationships of Leucine and Isoleucine with BAT2 Gene of Saccharomyces cerevisiae on High Alcohols and Esters" Genes 13, no. 7: 1178. https://doi.org/10.3390/genes13071178
APA StyleZhang, L., Zhang, Y., & Hu, Z. (2022). The Effects of Catabolism Relationships of Leucine and Isoleucine with BAT2 Gene of Saccharomyces cerevisiae on High Alcohols and Esters. Genes, 13(7), 1178. https://doi.org/10.3390/genes13071178

